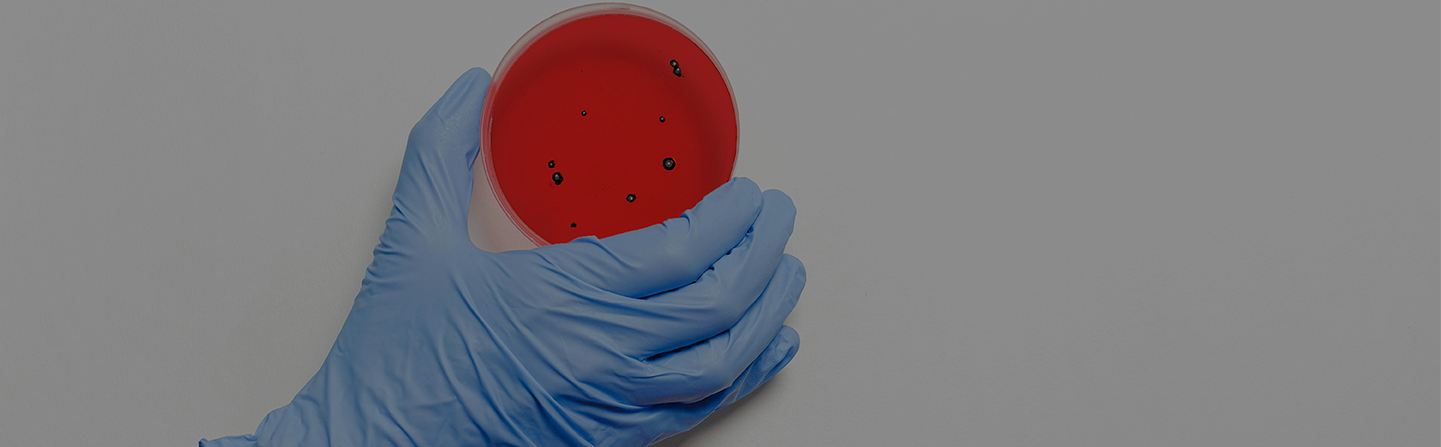
Anatomia Patològica i Citodiagnòstic +1

D'altra banda, col·laboraràs en la realització de necropsis clíniques i forenses, les quals serviran com a suport al diagnòstic clínic o metge.
Hauràs d'organitzar i programar el treball complint amb criteris de qualitat del servei i optimització de recursos, tot sota la supervisió facultativa corresponent.
Una vegada finalitzis el grau de Formació Professional d'Anatomia patològica i citodiagnòstic, et submergiràs en el món laboral amb l'ajuda de la nostra borsa de treball o encaminar-te cap a altres estudis com l'educació superior universitària.
Pla d'estudis cfgs Anatomia Patològica i Citodiagnòstic +1
- M4 Necròpsies
- M5 Processament citològic tissular
- M6 Citologia general
- M7 Citologia ginecològica
- M14 Projecte de anatomia patològica i citodiagnòstic
- M15 Ampliació fisiopatologia general
- M16 Eines digitals aplicades a l'anatomia patològica
Metodologia docent
Tutors Anatomia Patològica i Citodiagnòstic +1
Comptem amb docents professionals de les assiganturas que imparteixen, facilitant l'ensenyament amb pràctiques de casos reals.

Titulació homologada
Escola Ramón y Cajal és un Centre Oficial de Formació Professional autoritzat per les diferents Administracions Competents. En Escola Ramón y Cajal obtindràs la teva titulació Oficial de Formació Professional (FP) sense necessitat de realitzar cap prova externa, és a dir, no dependràs de les convocatòries d'obtenció directa de Títols de Formació Professional. D'aquesta manera, podràs aprofitar-te de tots els avantatges que ofereix la Formació Acadèmica Oficial sense la necessitat de desplaçaments i burocràcia. Nosaltres ens encarreguem de tot.


Sortides laborals Anatomia Patològica i Citodiagnòstic +1
Accés a la universitat
- La nota que hagis obtingut en el curs de Anatomia patològica i citodiagnòstic (sobre 10) equival a la nota total del batxillerat més la part general de la Selectivitat. Així doncs únicament hauràs de realitzar les assignatures optatives de la Selectivitat (part específica).
- Hauràs de comprovar quines assignatures optatives ponderen més per a accedir al grau universitari desitjat (una ponderació de 0,2 que equival a poder obtenir 2 punts més sobre la nota final d'accés al grau universitari).
- El càlcul final serà el següent: nota final CFGS + (nota examen x 0,2) = Nota final accés universitat.
Adaptabilitat curs i facilitat de pagament
El nostre centre compta amb la certificació oficial de Centre Oficial de Formació Professional, conseqüentment els nostres alumnes/as no percebran cap diferència amb un centre públic més enllà d'haver de costejar-se el curs. A Ramón y Cajal entenem totes les situacions econòmiques, així doncs, ens adaptem a la situació de cada alumna/e. Per això genèricament oferim dues modalitats de pagament estàndard que poden modificar-se adaptant-se a cada cas particular.
D'altra banda, també ens adaptem a les diferents necessitats didàctiques. A Ramón y Cajal la nostra prioritat és el teu futur i la qualitat d'aquest, així que estudiem cada cas detingudament i proposem solucions perquè el transcurs del curs i la durada del mateix sigui el més òptim possible per a l'estudiant, ens adaptem a tu.


Anima't a aprendre i a començar el teu futur amb nosaltres!
Accés a cicles formatius de grau superior a través de; titulació en graus superior o mitjà, certificació acadèmica de batxillerat o equivalent o a través d’una prova d’accés a grau superior.
Matriculació en línia